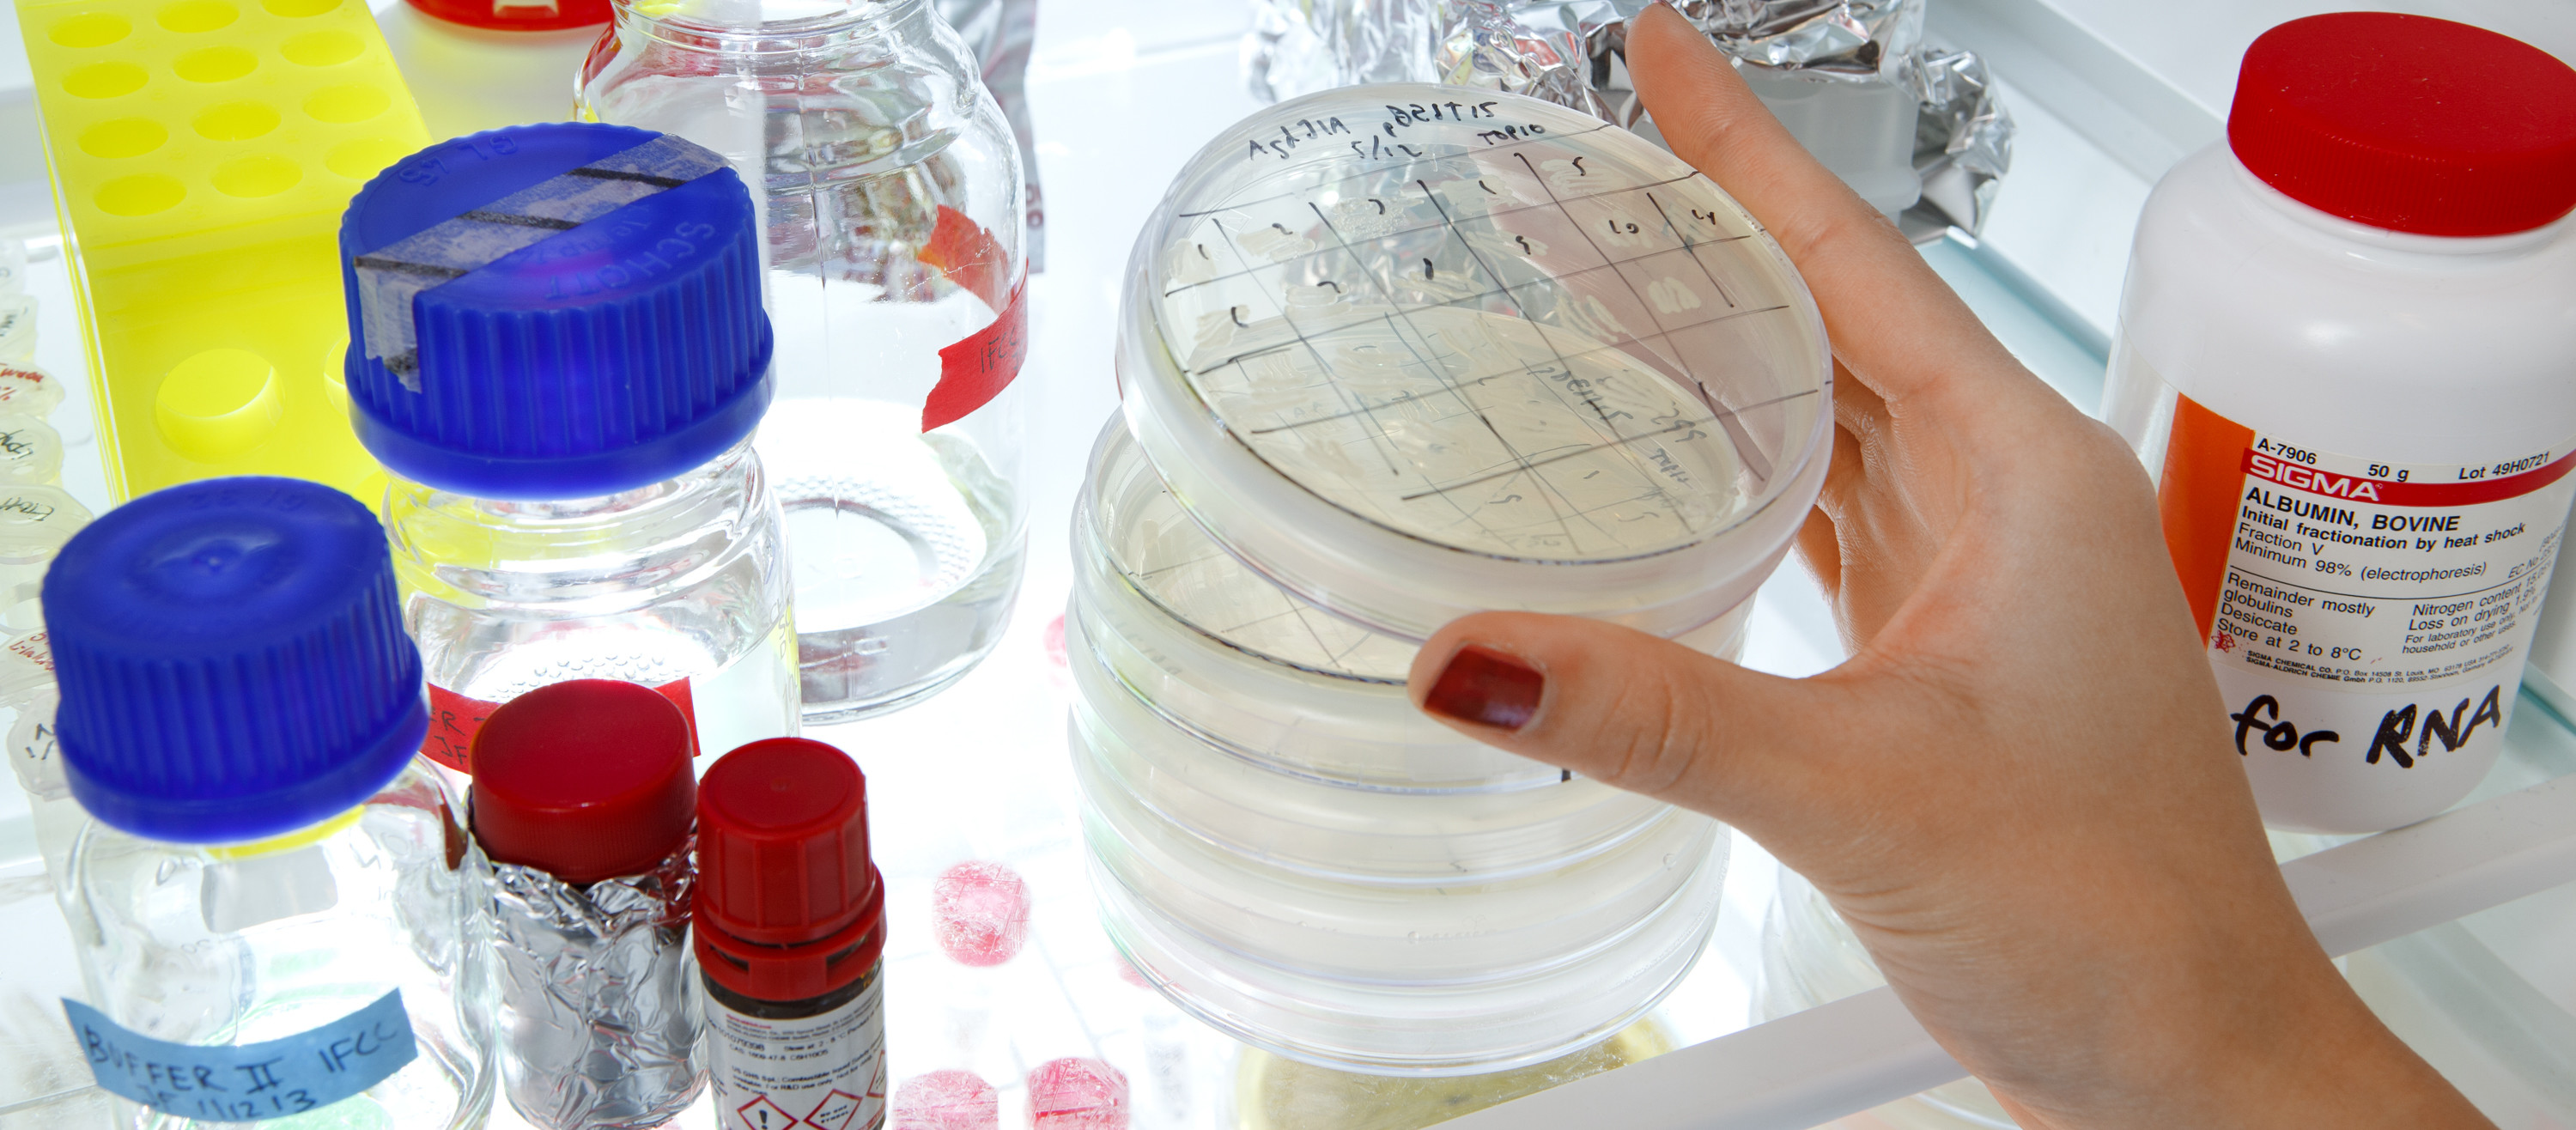

Våra utbildningar
Skolan för kemi, bioteknologi och hälsa erbjuder fyra doktorsprogram.
Forskarutbildningar på CBH-skolan
Teknik och hälsa
Medicinsk teknologi
Kemivetenskap
Bioteknologi
Kontakt
Kontakta oss på: phdadmin@cbh.kth.se
